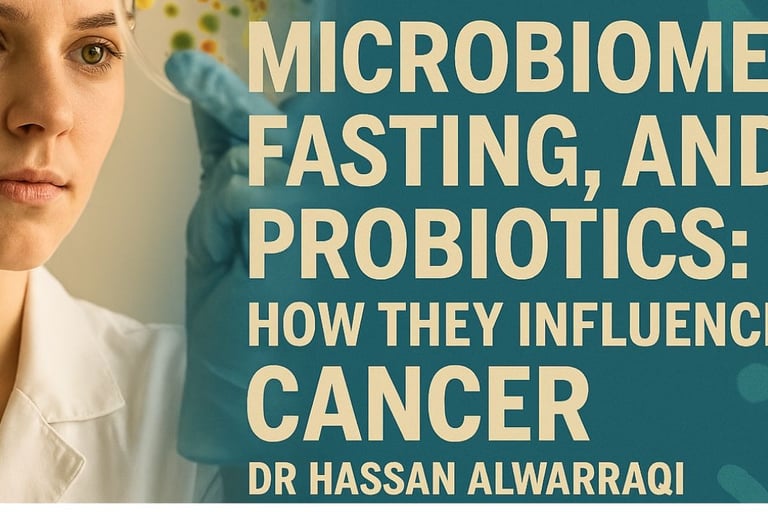

Health is a crown on the heads of the healthy that only the sick can see.

🧬 Microbiome, Fasting, and Probiotics: Their Effect on Cancer
"🧬 Discover how fasting and probiotics influence the gut microbiome and their potential role in cancer prevention and treatment. Learn the science behind this powerful connection."🔬🥦⏳
AUTOIMMUNE DISEASESGENERAL
Dr Hassan Al Warraqi
5/27/2025


🧬 Microbiome, Fasting, and Probiotics: Their Effect on Cancer
"🧬 Discover how fasting and probiotics influence the gut microbiome and their potential role in cancer prevention and treatment. Learn the science behind this powerful connection."
The growing understanding of the human microbiome's role in health and disease has revolutionized cancer research.
This comprehensive analysis explores the complex relationships between the microbiome, voluntary fasting, and probiotics in cancer development, progression, and treatment response.
These interconnected factors represent a new frontier in personalized cancer care and prevention strategies.
The Microbiome's Impact on Cancer Progression and Treatment Response
Microbiome-Immunity Connection
The human microbiome, particularly within the gastrointestinal tract, plays a pivotal role in immune system modulation.
Commensal bacteria function as immune system calibrators, fine-tuning the activation threshold of innate antiviral immunity.
These beneficial microorganisms contribute to the development of peripheral regulatory T cells (Tregs) and T helper 17 cells (Th17), both crucial components of immune response regulation.
The microbiome's influence extends beyond local immunity, affecting hematopoiesis and enhancing systemic immunity against bacterial infections.
When microbiome balance is disrupted (dysbiosis), it can trigger pro-inflammatory immune responses and initiate disease processes, including cancer development.
Microbiome and Cancer Development
Research has established clear connections between microbiome imbalance and tumor formation, not only in localized gastrointestinal cancers but also in tumors at distant body sites.
Scientists have identified ovarian cancer-specific microbiomes, termed "tumor microbiomes," highlighting the systemic nature of microbial influence on cancer.
Specific bacterial species like Fusobacterium nucleatum actively promote intestinal tumor formation while modifying the tumor's immune microenvironment.
The microbiome's influence spans the female reproductive tract, with vaginal microbiome composition potentially contributing to cervical cancer development.
Microbiome and Anti-Cancer Treatment Response
Emerging evidence demonstrates that commensal bacteria can control cancer treatment responses by modifying the tumor microenvironment.
Specific bacterial strains, including Enterococcus hirae and Barnesiella intestinihominis, may facilitate the therapeutic immune effects of cyclophosphamide chemotherapy.
The microbiome serves as a predictive biomarker for anti-PD-1 treatment response in metastatic melanoma patients.
Fecal microbiota transplantation (FMT) has been proposed as a potential strategy to enhance anti-PD-1 immunotherapy responses in advanced melanoma cases.
Innovative approaches include using tumor-targeting bacteria (such as engineered Salmonella) as delivery systems for cancer gene therapy.
Bacteria also influence radiotherapy responses, with studies showing microbiome regulation of intestinal radiation sensitivity.
Probiotics have been successfully used to prevent radiation-induced diarrhea in cervical cancer patients.
Microenvironment Consider Tumor rations
The post-radiotherapy tumor microenvironment represents a critical research area related to resistance mechanisms and cancer recurrence.
Tumor lymphocyte infiltration serves as a prognostic indicator in resectable non-small cell lung cancer, while high-dimensional single-cell analysis can predict anti-PD-1 immunotherapy responses.
Clinical Impact of Fasting on Cancer
Defining Intermittent Fasting and Time-Restricted Eating
Intermittent fasting (IF) involves abstaining from food and/or beverages for varying time periods, distinct from continuous caloric restriction.
Time-restricted eating (TRE) represents a specific IF form following circadian eating patterns that limit food consumption to defined daily or near-daily time windows.
TRE typically involves eating windows of 6-12 hours, requiring at least 12 hours of fasting to achieve a 20% or greater reduction in blood glucose and hepatic glycogen depletion.
Religious fasting practices, such as Ramadan fasting, can be considered forms of TRE.
TRE Mechanisms of Action
TRE influences metabolic balance by aligning eating windows with circadian rhythms.
This synchronization increases plasma membrane redox system enzyme concentrations and nicotinamide adenine dinucleotide (NAD+) production, both essential for sirtuin 1 (SIRT-1) activation.
SIRT-1 subsequently promotes gluconeogenesis while inhibiting circadian clock mechanisms, creating cascading metabolic effects that may influence cancer biology.
TRE Effects on Metabolic and Body Composition Markers
Studies in breast cancer survivors demonstrate TRE-induced reductions in visceral adipose tissue, total body fat mass, and overall body weight.
Research suggests TRE's protective associations may result from the intervention itself, even when accounting for other dietary factors and comorbidities.
TRE and Inflammation
Studies examining IF's effects on circulating inflammatory markers (CRP, TNF-α, IL-6) have yielded inconsistent results. However, exploratory research indicates that 17-19 hour daily fasting for 30 days in healthy young males stimulated expression of inflammatory genes NLRP3 and IL-1β.
TRE's Impact on Gut Microbiome
Systematic reviews indicate that IF produces significant gut microbiome shifts.
Microbiome composition substantially affects bile acid metabolism, potentially producing compounds like deoxycholic acid (DCA), lithocholic acid, and ursodeoxycholic acid (UDCA), which directly influence carcinogenesis across various cancer types.
A feasibility study of TRE in chronic lymphocytic leukemia and small lymphocytic lymphoma patients showed significant changes in secondary bile acids UDCA and DCA, plus branched-chain fatty acids.
Research demonstrates that TRE can alter gut microbiome diversity (both alpha and beta diversity), though results may vary between studies and IF types.
Longer fasting periods may favor growth of specific bacteria like Akkermansia muciniphila and Lachnospiraceae, which can ferment mucus and resist environmental changes from reduced food intake.
Findings suggest gut microbiome structures differ significantly before and after Ramadan, potentially returning to baseline after fasting cessation, indicating reversible TRE effects.
Studies show considerable homogeneity in compositional changes among fasting groups, with bacteria significantly affected by IF varying substantially between studies.
Significant IF-induced decreases in Veillonellaceae and Negativicutes families may represent beneficial changes, as Veillonellaceae is considered pro-inflammatory.
Increased prevalence of Proteobacteria and Gammaproteobacteria has been associated with dysbiosis and inflammatory diseases, suggesting IF-induced changes in these groups may have clinical significance.
Potential Health Implications of IF-Induced Microbiome Changes
Alpha diversity serves as a common gut microbiome health indicator, with higher diversity associated with "robust stability" and ecological function, plus multiple health indicators.
Decreased diversity levels indicate acute and chronic diseases.
Gut microbiome metabolism, including short-chain fatty acid (SCFA) production, affects intestinal barrier function and immune/inflammatory responses. SCFAs, particularly butyrate, may have beneficial effects on intestinal barrier integrity.
The Role of Probiotics in Cancer Prevention
Gut Microbiome and Health
The gastrointestinal tract houses a complex, dynamic community of microorganisms that significantly influence host health.
Firmicutes and Bacteroidetes dominate the human gut microbiome composition.
Multiple factors can alter gut microbiome composition, leading to dysbiosis that may trigger pro-inflammatory immune responses and initiate disease processes, including cancer development.
Probiotic Effects on Cancer Cells in Laboratory Studies
Various probiotic strains, particularly Lactobacillus and Bifidobacterium species, demonstrate a range of anti-cancer effects against different cancer cell lines in vitro.
These effects include reduced cell proliferation, G1 cell cycle arrest, apoptosis induction, and inhibition of cancer cell colony formation.
Probiotic Effects in Animal Tumor Models
Animal studies show decreased tumor incidence (TI), tumor progression (TP), tumor volume (TV), and tumor multiplicity (TM) following treatment with various probiotic strains.
Proposed mechanisms include apoptosis induction, cell cycle inhibition, and intestinal barrier improvement.
Production of Anti-Cancer Compounds
Probiotics produce metabolites including organic acids (lactic and acetic acid), hydrogen peroxide, and bacteriocins, which have inhibitory effects on pathogenic microorganisms.
Short-chain fatty acids (SCFAs), end products of intestinal bacteria metabolism, are important for maintaining colon health.
SCFAs serve as energy sources for colonic cells while promoting acidity and apoptosis in cancer cells.
Butyric acid contributes to colorectal cancer prevention by improving intestinal barrier function and increasing mucus production.
Probiotics can influence conjugated linoleic acid (CLA) production, which exhibits anti-cancer properties.
Intestinal Barrier Modification
Gut microbiome microorganisms can alter intestinal barrier permeability.
Certain probiotics can reduce intestinal permeability by modifying intestinal barrier components such as intracolonic pH, mucin production, and tight junction proteins.
Low intracolonic pH can inhibit pathogenic and putrefactive bacteria proliferation and bacterial enzyme activity responsible for carcinogenic compound production.
Some probiotic strains demonstrate ability to inhibit pathogen growth, including Helicobacter pylori and enteropathogenic Escherichia coli.
Probiotics can regulate intracellular pH, allowing survival and metabolic activity maintenance in relatively low pH environments.
Probiotics can increase mucin production (forming protective intestinal layers) by elevating MUC gene expression levels, particularly MUC2.
Additional Anti-Cancer Mechanisms
Probiotics can bind carcinogenic compounds in the digestive system, reducing their absorption. They influence the immune system, including natural killer (NK) cells and cytokine production.
Key Shared Themes
Central Importance of the Microbiome
All research emphasizes the fundamental role of the microbiome, especially the gut microbiome, in maintaining health and influencing cancer development and treatment response.
Immune Modulation
The microbiome's role in modulating immune responses directly affects cancer surveillance and immunotherapy treatment responses.
Microbial Metabolites
The importance of microbe-produced metabolites (such as SCFAs and bile acids) in influencing host health and carcinogenesis is consistently highlighted.
Diversity and Dysbiosis
Microbiome health correlates with diversity, while dysbiosis can lead to negative outcomes, including increased cancer risk.
Dietary Interventions
Both IF (including TRE) and probiotics represent potential dietary interventions for microbiome modification and cancer development/treatment influence.
Additional Important Facts and Insights
Historically, bacteria-based therapies (such as Coley's toxins) have been used in cancer treatment since the late 19th century.
The microbiome can influence mental health and behavior, while microbiome research methods (such as 16S ribosomal RNA sequencing) and diversity assessment represent important aspects for understanding intervention effects.
The need for additional research, particularly clinical trials, to understand and apply these findings in cancer contexts remains critically important.
Frequently Asked Questions (FAQs)
Q1: How does the microbiome directly influence cancer development?
The microbiome influences cancer development through multiple mechanisms including chronic inflammation induction, production of carcinogenic or protective metabolites, immune system modulation, and direct cellular interactions.
Specific bacteria like Helicobacter pylori cause chronic stomach inflammation leading to gastric cancer, while beneficial bacteria produce protective compounds like butyrate that have anti-cancer properties.
Q2: Can intermittent fasting prevent cancer?
While intermittent fasting shows promising effects on cancer-related biomarkers and microbiome composition, definitive evidence for cancer prevention in humans requires more clinical trials.
Animal studies and preliminary human research suggest IF may reduce cancer risk through improved metabolic health, enhanced immune function, and beneficial microbiome changes, but individuals should consult healthcare providers before implementing fasting protocols.
Q3: Which probiotic strains are most effective against cancer?
Lactobacillus and Bifidobacterium species show the strongest anti-cancer effects in laboratory and animal studies.
Specific strains like Lactobacillus acidophilus, Lactobacillus casei, and Bifidobacterium longum demonstrate ability to inhibit cancer cell growth, enhance immune function, and produce protective metabolites.
However, optimal strains may vary by cancer type and individual microbiome composition.
Q4: How long does it take for fasting to change the microbiome?
Microbiome changes can begin within 24-48 hours of fasting initiation, with more substantial shifts occurring over longer periods.
Studies show significant microbiome alterations during Ramadan fasting (approximately 30 days), though changes may be reversible upon resuming normal eating patterns.
The timeline varies based on fasting duration, individual baseline microbiome, and overall health status.
Q5: Is fecal microbiota transplantation safe for cancer patients?
FMT shows promise for enhancing cancer immunotherapy responses, but safety considerations are paramount for cancer patients with compromised immune systems.
While some clinical trials are investigating FMT in cancer treatment, it should only be performed under strict medical supervision with carefully screened donors and appropriate patient selection criteria.
Q6: Can probiotics interfere with chemotherapy?
Probiotics may actually enhance chemotherapy effectiveness in some cases, but potential interactions exist.
Some probiotic strains can influence drug metabolism and immune responses, potentially affecting treatment outcomes.
Cancer patients should always consult their oncology team before starting probiotic supplements to ensure compatibility with their specific treatment regimen.
Q7: What dietary changes support a healthy cancer-fighting microbiome?
A diverse, fiber-rich diet supports beneficial bacteria that produce protective SCFAs.
Foods like fermented vegetables, yogurt, kefir, prebiotic fibers, and polyphenol-rich fruits and vegetables promote microbiome health.
Limiting processed foods, excessive sugars, and unnecessary antibiotics helps maintain microbial diversity crucial for cancer prevention.
Q8: How does antibiotic treatment outcomes? use affect cancer
Antibiotic use can significantly disrupt beneficial gut bacteria, potentially reducing immunotherapy effectiveness and increasing treatment-related complications.
While sometimes necessary for infection prevention in immunocompromised cancer patients, antibiotics should be used judiciously, and microbiome restoration strategies may be beneficial following antibiotic courses.
Q9: Are there risks to intermittent fasting for cancer patients?
Cancer patients face unique considerations with fasting, including potential for malnutrition, interference with treatment schedules, and individual health complications.
While some studies suggest benefits, fasting protocols should only be implemented under medical supervision with careful monitoring of nutritional status, treatment response, and overall health.
Q10: How can individuals assess their microbiome health?
Microbiome testing through stool analysis can provide insights into bacterial diversity and composition, though interpretation requires expertise.
Clinical indicators include digestive health, immune function, and overall well being.
Working with healthcare providers familiar with microbiome science helps ensure appropriate testing and intervention strategies.
Conclusion
The evidence strongly suggests that the gut microbiome plays a vital role in host health, cancer development, and treatment response.
Interventions such as time-restricted eating and probiotics can modify microbiome composition and function, potentially offering new strategies for cancer prevention and treatment.
The complex interactions between the microbiome, fasting, and probiotics represent an emerging field with significant therapeutic potential.
However, more research, particularly well-designed clinical trials, is needed to fully explore these complex relationships and translate findings into effective clinical applications.
Future cancer care may increasingly incorporate personalized microbiome-based interventions, combining traditional treatments with targeted dietary modifications, probiotic therapies, and fasting protocols tailored to individual patient needs and microbiome profiles.
Keywords
The gut microbiome, combined with fasting and probiotics, represents a promising axis in the fight against cancer.
It modulates the immune response through the formation of regulatory T (Treg) and Th17 cells, and produces short-chain fatty acids (SCFAs) such as butyrate, which induce apoptosis of cancer cells and strengthen the gut barrier.
Microbial dysbiosis is associated with chronic inflammation and tumorigenesis, while the microbiome enhances the effectiveness of immunotherapies such as PD-1 inhibitors, particularly with bacteria such as Akkermansia muciniphila, and mitigates the side effects of chemotherapy and radiation.
Time-restricted fasting (TRE) stimulates autophagy and NAD+ production, inhibiting cancer cell growth and increasing beneficial bacteria such as Lactobacillus.
Meanwhile, a fasting-mimicking diet (FMD) has been shown to reduce colon tumor size by 57% in mice. Probiotics, such as Lactobacillus rhamnosus GG, inhibit the proliferation of cancer cells, enhance natural killer (NK) cell activity, and support chemotherapy and immunotherapy.
The synergy between fasting and probiotics, along with a high-fiber diet, enhances protection against cancer, but challenges lie in individual differences and the need for larger clinical trials to determine optimal dosages and ensure efficacy and
✍️ About the Author
Hassan Al-Warraqi is the founder of H-K-E-M.com and a health content creator focused on the intersection of nutrition, immunity, and chronic disease. His work delves into how the gut microbiome, fasting, and probiotics can influence inflammation, cellular repair, and even cancer risk.
In this article, Hassan explores how modulating the gut environment through dietary strategies may offer a supportive role in cancer prevention and therapy, grounded in emerging scientific evidence.
https://h-k-e-m.com/-microbiome-fasting-and-probiotics-their-effect-on-cancer
📱 Short Social Media Version
🖋️ By Hassan Al-Warraqi
Founder @h_k_e_m_com | Gut health, fasting & probiotics in cancer prevention 🧬🥦🌿

Get in touch
Address
Cairo Al Rehab
Contacts
+20 109 405 2056
hassanalwarraqi@h-k-e-m.com
